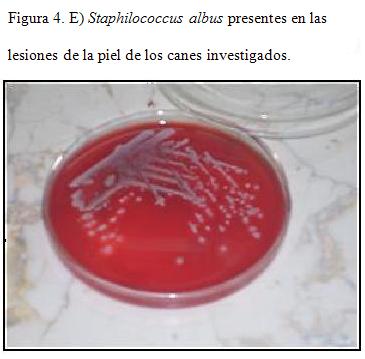

Serviços Personalizados
Journal
Artigo
Links relacionados
Compartilhar
Veterinaria (Montevideo)
versão impressa ISSN 0376-4362versão On-line ISSN 1688-4809
Veterinaria (Montev.) vol.51 no.197 Montevideo maio 2015
Actividad acaricida del aceite esencial del Azaridactha Indica en el tratamiento de la sarna demodécica del perro
Acaricide activity of the essential oil of Azaridactha Indica in the treatment of dog demodecic scabies
Labrada Hechavarría Y1, Cordoví Velázquez JM2, Rapado Paneque M3, Perdomo Rivera R4.
1. Centro de Estudio de Química Aplicada. Universidad de Granma. Carretera vía Manzanillo, km 171/2 Peralejo. Granma. Cuba. CP: 85 100. Teléfono: (53) (023) 42-4403. E-mail: yosvanis@eah.grm.hidro.cu
2. Laboratorios de Líquidos Orales (MEDILIP). Departamento de Investigación y Desarrollo. Carretera vía Santiago de Cuba,km845.Bayamo. Granma. CP: 85100. Teléfono: (53) (023)(48-7507 al 09) Ext. (153), e-mail: jmcordv@yahoo.es
3. Centro de Aplicaciones Tecnologías y Desarrollo Nuclear (CEADEN). Departamento de Radiobiología. Calle: 30 Nº 502 e/ 5ta Ave y 7ma.Playa. Teléfono: (53) (07) (202-2566 al 69),e-mail: rapado@ceaden.cu
4. Centro de Estudio de Química Aplicada. Universidad de Granma. Carretera vía Manzanillo,km 171/2 Peralejo. Granma. Cuba. CP: 85 100. Teléfono: (53) (023) (48-1015),e-mail: rperdomor@udg.co.cu
Recibido: 20/10/2014 Aceptado: 28/1/2015
Resumen
Con el objetivo de evaluar la actividad acaricida del aceite esencial del Azaridachta Indica (AE) frente al Demodex canis, agente causal de la sarna demodécica se analizaron los efectos a diferentes dosis. En el estudio in vivo se utilizaron 30 animales separados en dos grupos: 12 hembras y 12 machos, con diagnóstico de sarna demodécica positivo luego de raspado de piel. Se aplicaron diferentes concentraciones del biopreparado (1%, 10% y 20%). Las dosis estudiadas resultaron efectivas en el tratamiento contra el acaro Demodex canis. Los resultados se compararon obtenidos entre los niveles estudiados, entre los sexos para cada nivel de y las tasas de recuperaciones medias a través de los análisis estadísticos de rangos múltiples, por diferencias mínimas significativas (LSD) para un 95% de confianza. La formulación del biopreparado al 1%, desde el punto de vista clínico, toxicológico y económico, mostro ser la dosis más adecuada.
Palabras clave: Palabras claves: sarna demodecida, biopreparado, aceite esencial
Abstract
With the aim to evaluate the acaricide activity of the essential oil of the Azaridachta Indica (AE) in front of the Dermodex canis, causal agent of demodectic mange, the effects, to different dose, were examined. In the study in vivo were used sample of 24 animals separated in two groups: 12 females and 12 males, with positive diagnosises of demodectic mange to the scraped of skin. Animals were trated with preparations to different concentrations (1%, 10% and 20%). The studied dose turned out to be effective in the treatment against the acarusDemodex canis. The results were compared to the obtained for each level of concentrations studied, between the sexes and the taxes of average recoveries; through analysis of multiple ranges, for lower significant difference (LSD) to 95% of confidence. The formulation of the biopreparation to the 1 %, from the clinical, toxicological and economic point of view, proved to be the best-suited dose.
Keywords: mangedemodecic, biopreparation, essentialoil
Introducción
El árbol Nim (Azadirachta indica) constituye en la actualidadun recurso biológico de gran valor, con aplicaciones para la Medicina Veterinaria, salud humana y agricultura en sentido general, destacándose sus propiedades acaricidas contra insectos dañinos entre otras. Se ha comprobado en la práctica las posibilidades de producir por medios artesanales y a través de tecnologías industriales, productos bioinsecticidas derivados del Nim, efectivos contra una gama considerable de especies de insectos, ácaros, nematodos que constituyen plagas de importancia económica en la agricultura cubana, habiéndose notificado a nivel internacional su efectividad en más de 360 especies de ellos (Estrada, 2002).
En las condiciones de Cuba el parasitismo es un factor que afecta la salud en canes, influyendo en la elevación de las tasas de morbilidad y mortalidad sobre todos de los animales jóvenes (Estrada, 2003).
Jeleva (1989) refirió que la sarna es unas de las enfermedades más frecuente y se presenta casi en todas las partes del mundo. En condiciones ordinarias, alcanza la difusión máxima en animales pocos cuidados, deficientemente alimentados y que viven agrupados.
En nuestras condiciones existen dos tipos de afectaciones causadas por ácaros de diferentes géneros: la sarna demodécica producida por el Demodex y la sarna sarcóptica producida por el Sarcóptes Scabieivar, Demodex canis (Acari, Demodicidae), es un ácaro común de la piel de los caninos, y puede causar la enfermedad en la piel en casos de depresiones inmunes por parte del hospedero con síntomas que incluyen alopecia difusa o localizada, eritema, comedones asociados con dermatitis pustular y papular (Pérez, 2008).
Brechel, y col. (1995) recomiendan utilizar el polvo de hojas secas en forma de extracto acuoso, por otra parte Sáez (2003) refiere que el Nim se puede aplicar en forma de solución acuosa de semillas secas molidas para el tratamiento de algunos ectoparásitos del bovino.
Pérez (2008) refiere que el Nim presenta como compuesto activo más importante, la azadirachtina que interfiere en la metamorfosis de las larvas de los insectos, evitando que se desarrollen en crisálidas y por tanto mueren sin producir una nueva generación ya que interfiere el proceso de la fecundación y la salanina que actúa como repelente contra insectos; conociendo que varios extractos del Nim actúa en diversos insectos de diferentes maneras:
La evaluación del potencial farmacodinámico de los subproductos de las plantas medicinales, tal como sus aceites esenciales, constituye hoy en día una necesidad para lograr medicamentos alternativos, más efectivos y menos costosos, que pudieran sustituir a algunos de los fármacos utilizados actualmente. Especial importancia en este sentido se le ha dado a la búsqueda de agentes acaricidas, teniendo en cuenta que los ácaros han desarrollado una elevada resistencia a los acaricidas comerciales empleados hasta el momento (Shipstone, 2000; Abad, 2004; Mendivelso y col. 2007).
A pesar de no ser un patología altamente contagiosa, a causa de la localización del acaró (Demodex canis) agente etiológico de esta dermatopatía, el estrés ambiental, la alimentación y las complicaciones secundarias (pioderma), entre otros factores, como el costo de los fármacos empleados actualmente, hacen que las terapias empleadas hasta el momento aún no sean del todo exitosas. Por tal motivo, la búsqueda de nuevas sustancias eficaces y seguras para el tratamiento y control demodicosis canina, constituye una problemática actual.
El presente se propone evaluar la efectividad del biopreparado del aceite esencial del Azaridactha Indica a diferentes concentraciones como acaricida en el tratamiento de la sarna demodécica canina.
Materiales y métodos
Extracción del aceite esencial del Azaridachta Indica
Para la extracción del aceite esencial del Nim (AE), como ingrediente farmacéutico activo (IFA) se realizó la técnica “prensado al frío” (Hernández y col., 2005). Todo el AE extraído se almacenó en frascos color ámbar para evitar la descomposición de la sustancia activa por acción de la luz, ya que muchos principios activos extraídos de plantas son fotosensibles.
Evaluación de la calidad microbiológica del aceite esencial del Azaridachta Indica
Los ensayos de límite microbiológico, según la Farmacopea de los Estados Unidos 35 Formulario Nacional 30 (USP35 NF30, siglas en inglés, United States Pharmacopeia 35) del AE se realizaron en el Complejo de Laboratorios Farmacéuticos Oriente UEB Bayamo en la Ciudad de Bayamo, provincia de Granma, Cuba. Se empleó tres métodos: Placa vertida para el conteo total de bacterias, hongos, y pruebas bioquímicas para el aislamiento e identificación de bacterias.
Formulación del biopreparado
Se utilizó un agitador marca IKA-RW-16 Basic de procedencia Alemana y una balanza microanalítica marca Sartorios TE –S13-DS, de procedencia alemana, para el pesaje de las proporciones tanto de AE al 1%, 10% y 20% (peso/peso) y el propilenglicol como excipiente de base. Se empleó un beaker de 500 mL de capacidad, con agitador en forma de hélice, se fue agregando en varias proporciones cuantitativamente de propilenglicol y de aceite esencial de 600 rpm a 960 rpm hasta obtener la mezcla homogénea y de calidad farmacéutica para medicamentos de uso tópico, según (USP35 NF30). Como control se empleó propilenglicol. Las emulsiones a diferentes concentraciones se envasaron en frascos de color ámbar (250 mL) para evitar la aceleración de la cinética de degradación por fotólisis. Todas las muestras fueron etiquetadas e identificadas.
Evaluación de la actividad acaricida del aceite esencial del Azaridachta indica
Ubicación del desarrollo del estudio
El estudio se realizará en la Clínica Veterinaria de Bayamo perteneciente al Instituto de Medicina Veterinaria del municipio Bayamo de la provincia de Granma, Cuba, durante el año 2014.
Utilización de los animales con lesiones dermatológicas
Se utilizaron canes de raza mestiza (n=24), 12 hembras y 12 machos con un peso corporal promedio entre 10-15 kg, con diagnóstico positivo de sarna demodecica, los cuáles fueron distribuidos aleatoriamente en 4 grupos de tratamientos. A cada uno de los animales se les realizó una historia clínica donde se recogió toda la información de datos individuales, antecedentes, anamnesis, conducta a seguir y tratamiento terapéutico.
Diagnóstico clínico-parasitológico-microbiológico
El diagnostico confirmativo de la enfermedad se realizó mediante Raspados cutáneos, según la técnica descrita por Rodríguez, y col (1987). Las muestras fueron colectadas de tres diferentes regiones anatómicas (dorso, tórax, extremidades anteriores y posteriores) de la economía animal. Cada raspado fuerealizado en un área de piel de aproximadamente 1 cm2. Las muestras fueron tomadas desde los días 0, (antes del tratamiento) y hasta después del tratamiento. Las muestras se conservaron en solución de KOH al 10 %, durante 15 min a temperatura ambiente, y fueron trasladadas hacia el Laboratorio de Parasitología de la Universidad de Granma, donde se realizó la identificación por método directo utilizando un microscopio estereoscopio marca Orión de procedencia China.
El número de estados inmaduros (larvas y ninfas), adultos y huevos fueron contados en cada raspado. Los animales también fueron clínicamente evaluados mediante la medición de la extensión de piel afectada y la descripción de las lesiones.
El principal criterio de eficacia fue analizado según lo siguiente:
Número de parásitos en animales tratados y no tratados, teniendo en cuenta todas sus formas vitales (larvas, ninfas, huevos, adultos). Según el número de parásitos, se estableció una gradación:
- 0: Ausente: 0 parásitos por campo.
- 1: Leve: £ 2 parásitos por campo.
- 2: Moderado: 3-5 parásitos por campo.
- 3: Severo: > 5 parásitos por campo.
Evolución de la sintomatología clínica de los animales en estudio: valoración del periodo de recuperación clínica. Para ello, el clínico responsable del estudio valoró los síntomas y lesiones: alopecia, comedones, descamación, eritema, pápulas, pioderma profunda, otitis y pústulas. Se asignaron valores según el grado de lesión, siguiendo la siguiente gradación:
- 0: Ausente
- 1: Leve
- 2: Moderado
- 3: Severo
Diagnóstico microbiológico
Paralelamente, se tomaron muestras de exudado de las zonas de la piel lesionada, con el objetivo de identificar el tipo de bacterias que de forma secundaria se encuentren afectando las lesiones cutáneas. Las muestras de exudado fueron tomadas mediante un hisopo. Las muestras fueron colocadas en tubos de ensayo conteniendo medio conservante Stuart universal y se trasladaron hacia el Laboratorio de Microbiología del Laboratorio Oriente UEB Bayamo donde se realizó la identificación bacteriológica, mediante el cultivo de las muestras en agar sangre universal, posteriormente las placas de cultivo fueron mantenidas en incubadora a una temperatura de 37 ºC durante 24 horas, transcurrido este tiempo se realizó la lectura del crecimiento de las colonias. El análisis microbiológico se realizó antes y después de los tratamientos.
Diseño experimental
Experimento 1
Los canes con diagnóstico positivo de sarna demodectica, fueron distribuidos de manera intencionada buscando la homogeneidad en el cuadro lesional de la enfermedad. Se conformaron 4 grupos experimentales, de 3 animales cada uno (sexo: macho). Al grupo 1 se le aplicó emulsión al 1%; al grupo 2, emulsión al 10%; al grupo 3 emulsión al 20% y al grupo control emulsión de propilenglicol sin AE (IFA) (Placebo o matriz).
Experimento 2
Los canes con diagnóstico positivo de sarna demodecica, fueron distribuidos de manera intencionada buscando la homogeneidad en el cuadro lesional de la enfermedad. Se conformaron 4 grupos experimentales de 3 animales cada uno (sexo: hembras). Al grupo 1 se le aplicó emulsión de AE 1%; al grupo 2, emulsión de AE al 10%; al grupo 3 emulsión de AE al 20% y al grupo control emulsión de propilenglicol sin AE (IFA) (Placebo o matriz).
Los tratamientos tópicos fueron aplicados dos veces al día previa limpieza de las lesiones con solución salina. Los animales fueron observados diariamente con el objetivo de controlar su evolución y el cumplimiento de la correcta aplicación de los tratamientos, bajo el mismo régimen de alimentación y manejo. Fueron observadas la posible aparición de reacciones adversas como edema y eritema, vómitos, nauseas, inherentes a los tratamientos.
La duración de los tratamientos, fueron hasta lograr el criterio de curación determinado este por tres raspados de piel consecutivos hasta que den negativos.
Evaluación de la actividad acaricida del aceite esencial del Azaridachta Indica
Diagnóstico clínico-parasitológico-microbiológico
Se evidencia en el siguiente gráfico 3 el número de parásitos en animales tratados y no tratados, teniendo en cuenta todas sus formas vitales (larvas, ninfas, huevos, adultos). Según el número de parásitos.
Procedimiento estadístico para el estudio in vivo
Comparación de los tratamientos entre los distintos niveles de concentración
Para el análisis de los resultados entre día se aplicó un procedimiento de comparación múltiple para determinar cuáles medias son significativamente diferentes de otras. Se observaron las homogeneidades de los grupos muestrales. El método empleado para discriminar entre las medias fue el procedimiento de diferencia mínima significativa (LSD) de Fisher.
Comparación de los tratamientos entre sexos
Se efectuó un análisis de rangos múltiples comparando la igualdad entre las medias por el método de LSD entre los sexos en cada tratamiento.
Comparación de los tratamientos por tasas de recuperación
Se determinó las tasas de recuperación para cada uno de los tratamientos comparando los días respecto al promedio de los días de recuperación de tratamiento del control (tratamiento con placebo), según la ecuación 1.
Se ejecutó la prueba de rangos múltiples. Se compararon los grupos a través del método de LSD para un 95 %. Las diferencias estadísticas posibles entre las tasas de recuperaciones de los tratamientos se determinaron con el análisis de contraste mínima diferencia significativa
Análisis económico de los gastos por tratamientos y toma de decisiones
Para el coste económico de la producción de 1 kg de las formulaciones para los diferentes tratamientos se tuvo en cuenta las cantidades del AE y propilenglicol utilizados; así como, los precios actualizados de cada materia prima. Se calculó mediante la ecuación 2.
El gasto por tratamiento se determinó incluyendo las cantidades aproximada de tratamiento diario, el precio del medicamento y los días promedio de tratamientos obtenidos para cada nivel. Se calculó a partir de la ecuación 3.
Resultados
Extracción del Aceite Esencial (AE) del Azaridachta Indica.
El cuadro I muestra los resultados del ensayo de límite microbiano practicado, NF 30 del 2012, los límites se establecieron teniendo en cuenta que el aceite es producto natural.
Formulación del biopreparado
Se obtuvieron los biopreparados con aceite esencial no irradiados como IFA, se prepararon concentraciones al 1%, 10% y 20% (peso/peso), con propilenglicol como excipiente de base; hasta obtener la mezcla con la homogeneidad deseada, empleándose como control propilenglicol. Las emulsiones a diferentes concentraciones se envasaron en frascos de color ámbar (250 mL), para evitar la aceleración de la cinética de degradación por fotólisis. Todas las muestras fueron etiquetadas e identificadas.
Procedimiento estadístico para el estudio in vivo.
Comparación de los tratamientos entre niveles de concentración.
En el cuadro II se identifican 3 grupos homogéneos, según la alineación de las X's en columnas. No existen diferencias estadísticamente significativas entre aquellos niveles que compartan una misma columna de X's.
Resultados del análisis económico y toma de decisiones
En el cuadro VII se calculó el costo de producción de un litro del AE Nim para los diferentes niveles de concentración de los tratamientos estudiados.
Discusion
Resultados de los métodos de ensayos para los conteos total de bacterias, hongos, levaduras y aislamiento de microorganismos del Aceite Esencial del Azaridachta Indica.
El cuadro I muestra los resultados del ensayo del límite microbiano practicado (USP 35 NF 30 del 2012). Los límites se establecieron teniendo en cuenta que el aceite es producto natural.
Se observó que después de practicados los análisis microbiológicos, las muestras se encuentran dentro de los límites especificados, cuando sólo se aíslan 20 ufc/mL, no sucediendo este proceso en ninguna de los especímenes originales de microorganismos patógenos, como Salmonella sppy Escherichiacoli, microorganismos que no deben estar presentes en el origen natural, por lo que la muestra del AE cumple con los límites microbianos según lo establece la USP 35.
Se evidencia en cuadro II las pruebas microbiológicas realizadas al aceite esencial para establecer parámetros microbiológicos lo que indica que el AE cumple con la calidad microbiológica para su uso en formulaciones farmacéuticas.
Evaluación de la actividad acaricida del aceite esencial del Azaridachta Indica.
Diagnóstico clínico – parasitológico – microbiológico.
En los canes que presentaron las formas localizadas, tanto hembras como machos, las lesiones estaban localizadas en la cabeza: base de las orejas, región periocular y hocico. Se caracterizaron por alopecia, eritema, descamación y prurito. También presentaron lesiones en el dorso del cuerpo, siempre acompañado de algunas en la cabeza, húmedo o seco.
En la forma generalizada como se evidencia en los gráficos A y B- para el sexo hembra y macho se comportó de un 7 a 20 %; en las lesiones secas se comportaron a 13 a 27 % y se caracterizaron por alopecia, descamación, eritema, prurito, foliculitis aislada y otitis externa. La generalización exudativa del proceso, fue la forma clínica que predominó sobre el resto, manifestándose de 27 al 20 % en ambos sexos. Estas se acompañaron también de otitis externa, depilación, erosión, foliculitis, exudado hemorrágico-purulento, costras y prurito, así como de un olor fétido que evidenciaba la presencia de contaminación secundaria. Los animales implicados presentaron síntomas de afectación general, mostrando decaimiento, fiebre (40 a 41ºC), inapetencia y linfadenitis de las extremidades posteriores.
La pododemodicosis se presentó como forma clínica independiente de la forma generalizada, se manifestó por lesiones eritematosas, alopecia y edema en los espacios interdigitales, con 13 a 20 %.
En los animales afectados predominaron las formas clínicas exudativas: localizada húmeda y generalizada húmeda en ambos sexos.
En el raspado de piel de los perros diagnosticados con demodicosis en ambos sexos, se observaron diversos estadios de ácaros del género Demódex, cuya morfología característica coincide con lo reportado por Reyes (2000), que refiere que los ácaros del género Demódex son pequeños, alargados, desprovistos de cerdas, de aspecto vermiforme, que terminan alargados en punta. Comunica que el género se divide en varias especies que difieren poco morfológicamente, pero que son específicas para determinados hospederos, siendo Demódex canis la que afecta al perro, alcanzando tallas de 300 x 40 μm el ejemplar adulto, y los huevos de 70 – 90 x 18 – 25 μm.
Se evidencia en el gráfico 2 el número de parásitos en animales tratados y no tratados, teniendo en cuenta todas sus formas vitales (larvas, ninfas, huevos y adultos), según el número de parásitos.
Se muestra en el gráfico 3 la evolución clínica de los animales en estudio, con el 17 % de lesiones leves, un 33 % de severo y un 50 % de moderado.
Diagnóstico microbiológico.
Con este resultado se demuestra que las heridas presentaron infecciones secundarias, como suele suceder en algunos casos clínicos con lesiones dérmicas originadas por el gusano barrenador, tal como lo refiere Domínguez, (2002).
Durante cada aplicación del medicamento se observa con frecuencia la presencia de pus en algunas heridas de los animales, en todos los grupos investigados, y en la medida en que la concentración del producto aumentaba, el número de animales con lesiones virulentas y cantidad de pus disminuían, resultados similares a los logrados en el tratamiento con hojas del árbol del Nim en lesiones dérmicas originadas por el gusano barrenador reportados por Sáez, (2003).
En el análisis bacteriológico se constata el crecimiento de colonias blancas no hemolíticas, redondas con bordes definidos Gram (+), morfológicamente compatibles con genero Staphilococcus albus; esta bacteria es considerada microflora normal de la piel, convertida en estos casos en patógena oportunista. Figura 3
Aunque Ingraham, y col. (1998) señalaron que hasta hace poco tiempo los Staphilococcus que habitan normalmente en la piel eran considerados inocuos, en la actualidad se ha comprobado que cualquier especie puede convertirse en patógeno, lo que se confirma en esta investigación, observándose además, que los animales evolucionaron 12 días después de la recuperación, clínica resultando negativos los exudados segregados de la piel.
Los resultados de esta investigación concuerdan con lo reportado por Rajeev, (2009), el cual comprobó que las hojas del árbol del Nim poseen propiedades anti-bacterianas y que detiene el crecimiento de Mico bacterias, y que las hojas pulverizadas con un extracto acuoso eliminan la dermatitis, sarnas e infecciones semejantes.
La investigación practicada está en consonancia con los estudios preliminares en laboratorios, que demuestran que el aceite del Nim ha tenido efectos significativos sobre varias cadenas de bacterias Gram positivos y Gram negativos, y que uno de los compuestos medicinales del Nim ha demostrado efectividad antibacteriana contra varios microorganismos como Staphilococcusaeureus, que causa la peritonitis, cistitis y meningitis, que es eliminada o puesta inactiva con dosis pequeñas de aceite del Nim. (Puri, 1999; Ibarra, 2003; Madruga, 2004)
Procedimiento estadístico para el estudio in vivo.
Comparación de los tratamientos entre niveles de concentración.
En cuadro II, el asterisco que se encuentra al lado de los 5 pares, indica que éstos muestran diferencias estadísticamente significativas con un nivel del 95,0% de confianza. A partir de estos resultados, se pude inferir que los tratamientos aplicados muestran diferencias respecto al de control o placebo. Sin embargo, existe una igualdad estadística entre los tratamientos A y el B.
Contraste de medias de los tratamientos de la prueba de Múltiple Rangos para los tratamientos a diferentes niveles de concentración.
El gráfico de medias, de la figura 5, corrobora la posible igualdad entre los tratamientos A y B, mientras que los restantes indican diferencias en días de recuperación respecto a los tratamientos anteriores y en sí. Esto se debe por la coincidencia parcial o total entre los rangos de variabilidades de los mismos.
Comparación de los tratamientos entre sexos.
En la tabla IV aparece el análisis de la comparación entre los sexos por tratamientos. Todos los casos mostraron diferencias estadísticas significativas para un nivel de confianza del 95 %, lo que indica que entre los sexos existen niveles de recuperación y respuestas a los tratamientos diferentes.
Contraste en la prueba de múltiples rangos de la comparación de los tratamientos respecto al sexo.
En la figura 6 se demuestra el comportamiento de las recuperaciones medias con sus variables entre los sexos. Los resultados están en concordancia con lo reportado en la literatura, presentando el sexo femenino recuperaciones mayores. Solo en el tratamiento al 10 % se mostraron superiores los machos, debido al grado de afectación en las hembras respecto a estos, no obstante observarse que la diferencia es mínima, a pesar de que Nayak y col. (1997)no encontraron diferencias en cuanto al sexo de los animales afectados. Sin embargo, Simón y Vergara, (2007), encontraron una proporción de hembras enfermas (53%) mayor que los machos (47%), obteniéndose resultados similares, lo que puede estar influido por los eventos estresantes que acontecen de manera sistemática en las hembras: celo, parto, lactancia y pseudogestaciones.
Comparación de los tratamientos por tasas de recuperación
El análisis de contraste de la diferencias mínimas significativas indican que existen diferencias reales entre los tratamiento A y C, así como entre B y C, corroborando la igualdad estadística de los dos primeros tratamientos. Los resultados estadísticos se muestran en el cuadro XII.
Prueba de contraste de las tasa de recuperaciones de los tratamientos.
Durante cada aplicación del biopreparado, se son frecuencia la presencia de pus en algunas heridas de los animales, en todos los grupos investigados, y en la medida en que la concentración del producto aumentaba, el número de animales con lesiones purulentas y cantidad de pus disminuían. Resultados similares obtuvieron Parra y col. (1994), que demostraron que extractos del Nim a una concentración de 1 y 10 % fue efectiva sobre las larvas de M. Latines en el tercerestadio, con una efectividad entre 93 y el 100 % de eficiencia, como insecticidas acumulativos sobre esta especie de plaga.
Resultados del análisis económico y toma de decisiones
En el cuadro VI se calculó el costo de producción de un litro de AE Nim para los diferentes niveles de concentración de los tratamientos estudiados.
Estadísticamente se mostró una tasa de recuperación diferente para al tratamiento C, que presenta una media 5,1 día. Esto es 1,67 días de diferencia respecto al tratamiento B y de 2,67 días para A. Al analizar el coste de producción de un kg del medicamento al 20 %, este asciende a € 1053,33. Sin embargo, para el 10%, el coste significa € 342,87 menos, por lo que la relación costo/beneficio indica que es conveniente la fabricación del medicamento al 10%. (Ver cuadro VI)
Cálculo del gasto de los tratamientos por animal
Teniendo en cuenta que en los análisis estadísticos realizados para los días de recuperaciones y las tasa de recuperación no mostraron diferencias significativas entre los tratamientos al 1% y el 10%, y considerando el gasto de producción/tratamiento/animal de € 110,14, se justifica adecuadamente, desde el punto de vista clínico, toxicológico y económico el empleo de la formulación al 1% de concentración. El ahorro económico estaría dado sobre los € 943,19 por tratamiento para cada animal afectado.
Pérez (2002)y Estrada (2003)señalaron que el Nim presenta como compuesto activo más importante la azadirachtina, que interfiere en la metamorfosis de las larvas de los insectos, evitando que se desarrollen en crisálidas y por tanto mueran sin producir una nueva generación, al interferir el proceso de la fecundación y la salanina, que actúa como repelente contra insectos; conociendo que varios extractos del Nim actúan en diversos insectos de diferentes maneras:
- Destruyendo e inhibiendo el desarrollo de huevos, larvas o crisálidas.
- Bloqueando la metamorfosis de larvas o ninfas.
- Destruyendo su apareamiento y comunicación sexual.
- Repeliendo a larvas y adultos.
- Impidiendo a larvas poner huevos.
- Esterilizando adultos.
- Envenenando a larvas y adultos.
- Impidiendo su alimentación.
- Bloqueando la habilidad para tragar (reduciendo la movilidad intestinal).
- Enviando mayores errores a su metamorfosis en varios períodos de desarrollo del insecto.
- Inhibiendo la formación de quitina (material del que se compone el esqueleto del insecto).
Impide que se realicen las mudas, necesarias para entrar en la siguiente etapa del desarrollo, actuando como regulador de crecimiento del insecto.
El tratamiento aplicado en forma de emulsión demostró tener marcada efectividad, coincidiendo con Sara, (2004), al señalar que en las semillas de Nim se encuentra la mayor concentración de sustancias activas.
Los resultados de esta investigación están en consonancia por lo reportado por Montañez, 2005,que planteó que el producto más valioso de la semilla es el aceite, que contiene azadirachtina (sustancia principal insecticida), presente en todas las partes del árbol de Nim, existiendo evidencias positivas en las concentraciones del 10 % al 20 % como muestra el gráfico en los grupos tratados.
No se coincide con lo planteado por Estrada, (2003), cuando refiere que una pasta cicatrizante con una concentración al 100% de Nim es muy efectiva en el tratamiento de algunas patologías entre las cuales se encuentra sarna demodécica. En este experimento se demuestra que con concentraciones al 1 %, 10 % y 20% se obtienen resultados favorables.
Conclusiones
- El aceite esencial a dosis de 1 al 20 % elimina el ácaro Demodex canis.
- El aceite esencial obtenido de las semillas del Azaridachta Indica entre el 1-20%presenta alta efectividad para el control del ácaro Demódex canis agente causal de la Sarna Demodécica.
- Se demostró que el propilenglicol es adecuado como solvente para la formulación del biopreparado.
Bibliografía
1. Estrada J. (2002). Potencialidades del uso del Nim y sus Bioproductos en: Revista Agricultura Orgánica (3). p: 21. Cuba.
2. Estrada, J: E. El Nim y sus bioinsecticidas, una alternativa agroecológica. ACPA (4): 39-48, 2003.
3. Jevela, M. Revista cubana de ciencias veterinarias. Ácaros oribátidos de los suelos pecuarios cubanos. Primera parte. (3), Vol4, 5, 1989.
4. Pérez G, Sigal G. (2008). Demodicosis en caninos y felinos. Disponible en: www.librosmedicos.com (consulta: 12 mayo 2008).
5. Brechel A, Fernández C. (1995) .El árbol para la agricultura y el medio ambiente. Experiencias en la República Dominicana. Revista Agricultura y medio ambiente. Cuba. 3:24 – 27.
6. Sáez CH. Cultura verde. (2003). El Nim árbol bendito (III parte) en: Periódico de la provincia de Cienfuegos. (en línea) (Citado 4 de marzo 2004)
7. Shipstone M. (2000). Generalised demodecosis in dogs, clinical perspective. Aust Vet J 78:240–242.
8. Abad RG. (2004). Metabolismo secundario en las plantas, p. 3-5, Bayamo.
9. Mendivelso DL, Olivares MC, Martínez JR, Stashenko E. (2007). Composición química de los metabolitos secundarios volátiles de Pelargoniumgraveolens, en función del método de extracción y época de recolección del material vegetal. Scientia Et Technica XIII (033), 183-184.
10. Hernández C, Mieres A, Nino Z, Pérez S. (2007). Efecto de la Refinación Física Sobre el Aceite de la Almendra del Corozo (Acrocomiaaculeata).Inf. tecnol. (Online). 2007, vol.18, n.5 (citado 2014-12-30), pp. 59-68.
11. United States Pharmacopeia 35, National Formulary 30. Rockville, Md., USA. The United States Pharmacopeial Convention, Inc. 2012.
12. Domínguez. J. Breves en: Contra el gusano barrenador en Centro América (en líne) 2002 (Consulta: 2013-11-14) Disponible en Internet: HYPERLINK "http://www" http://www.apsid.com.ak/muta.asp?cid/26_ims/a.htm
13. Rodríguez J, Alonso M, Blandino T, Abreu R, Gómez E. (1987). Manual de Técnicas Parasitológicas. Ediciones ENPES 11 – 12; 60.
14. Ingraham, JL, Ingraham CA. (1998). Flora normal de la piel en: Introducción a la Microbiología Tomo: II.. P: 341
15. Rajeev S. (2009). Aceite de Nim. (En línea) (Consultado: 22 de noviembre de 2012) (Citado: 3 de enero 2013) Disponible en: http://es.wikipedia.org/wiki/Aceite_de_nim
16. Puri HS. (1999). Neem: The Divine Tree. Azaridachta Indica. Harwood Academic Publications, Amsterdam. ISBN 90-5702-348-2.
17. Ibarra A, (2003). Agricultura Biológica: Introducción del Nim. Proyecto Cooperativa Cubano-Búlgara, Güines Habana, Cuba.
18. Madruga A,.Cobija de Buena sombra en: Periódico Granma. La Habana jueves 17 de junio. Año del 45 aniversario del asalto al cuartel Moncada. 2004.
19. Parra MJ, De Santis G, Carruyo R, Cardoso R, González N, Alcántara A. (2005). Manual de Plantas Medicinales. Botánica, Propiedades, Usos y Recetas, p. 8-22, Universidad Nacional Experimental Sur del Lago.
20. Reyes L, Ramos P. (2000). Enfermedades parasitarias del perro. Cuba: Científico- Técnica.
21. Pérez R. El árbol del Nim en: Revista ACPA. Cuba. 5 (4). p: 48-51. 2002. Experiencias en la República Dominicana. Revista Agricultura y medio ambiente. Cuba. 3 (4). p: 24 – 27.
22. Sara J. Boeke and Col. (2004). (Safety evaluation of Neem (AzadirachtaIndica) derived pesticides) Journal of Ethnopharmacology. Vol. 94, Num. 1, pp 25–42.
23. Montañez L. (2005). (Desarrollo de un Bioinsecticida a partir de la Azadiractina presente en el aceite de Nim (Azadirachta Indica). Trabajo Especial de Grado, Facultad de Ingeniería, Universidad de Carabobo, Venezuela.
24. Estrada JE. El Nim y sus bioinsecticidas, una alternativa agroecológica. Revista ACPA. Cuba. 6 (4): 39-48, 2003.